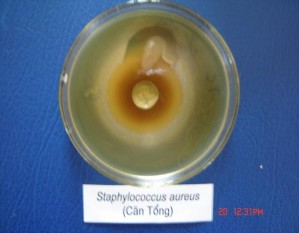
Hình 2 1 Ảnh được gây ức chế xung quanh giếng thạch Chúng tôi còn tiến hành 3
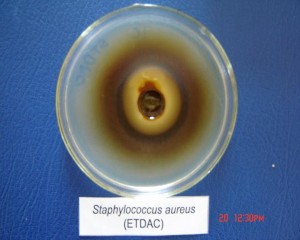
Hình 2 1 Ảnh được gây ức chế xung quanh giếng thạch Chúng tôi còn tiến hành 5

2.3.2. Khảo sát định tính các dịch chiết
Dùng các thuốc thử đặc hiệu để phát hiện các nhóm hợp chất thiên nhiên có trong hoạt tính sinh lí cao trong thực vật [3] chúng tôi thu được kết quả thử định tính với các nhóm chất, kết quả được chỉ ra ở bảng 2.2.
Bảng 2.2. Phát hiện các nhóm chất trong cây đỏ ngọn
Nhóm chất | Thuốc thử đặc hiệu | Hiện tượng | Kết quả | |
1 | Saponin | Tạo bọt | Bọt bền trong axit | ++ |
2 | Glicozttim | Kelle-Kiliani | Vàng nâu | - |
3 | Cumarin | Axit và kiềm | Kết tủa bông | ++ |
4 | Poliphenol | (FeCl3+K3[Fe(CN)6]) 1% | Xanh thẫm | +++ |
5 | Flavonoit | Xianidin | Từ hồng đến đỏ | ++ |
6 | Steroit | Liberman-Bourchard | Màu xanh vàng | ++ |
7 | Ancaloit | Dragendorf | Màu vàng da cam | - |
8 | Đường khử | Felinh | Cho kết tủa màu đỏ gạch | ++ |
Có thể bạn quan tâm!
-
Nghiên cứu hoá học và nhận dạng một số nhóm chất có trong cây đỏ ngọn (cratoxylum prunifolium kurtz) - 1 -
Nghiên cứu hoá học và nhận dạng một số nhóm chất có trong cây đỏ ngọn (cratoxylum prunifolium kurtz) - 2 -
Những Nghiên Cứu Hoá Thực Vật Loài Cratoxylum Prunifolium. -
Phổ 13 C-Nmr Và 1 H-Nmr Của Taraxeron (Đc-1) Từ Lá Đỏ Ngọn -
Phổ 13 C-Nmr Của Các Chất Đc-2 Và Stingmasterol [16] -
Số Liệu Phổ Nmr Của Đe-1 Và Số Liệu Phổ Nmr Trong
Xem toàn bộ 118 trang tài liệu này.
Ghi chú: Dấu (+) là có phản ứng dương tính, (++) là có phản ứng tính rất rõ, (-) là không có phản ứng.
2.3.3. Thử hoạt tính sinh học
Thử hoạt tính vi sinh vật kiểm định bằng định tính theo phương pháp khuyếch tán trên thạch, sử dụng khoang giấy lọc tẩm chất thử theo nồng độ tiêu chuẩn tại bộ môn Vi Sinh trường Đại học Y Thái Nguyên.
Các chủng vi sinh vật thử gồm đại diện các nhóm:
Vi khuẩn Gr (-) Escherichia coli.
Vi khuẩn Gr (+) Staphylococcus auresu.
Vi khuẩn: Salmonella typhi.

Hình 2.1. Ảnh được gây ức chế xung quanh giếng thạch
Chúng tôi còn tiến hành thử các ứng dụng làm thực phẩm chức năng tại cơ sở sản xuất kinh doanh thuốc thành phẩm, thực phẩm chức năng Y học cổ truyền Thái Nguyên. Kết quả thử hoạt tính các dịch chiết thô được trình bày trong bảng 2.3.
Bảng 2.3. Kết quả thử hoạt tính sinh học của dịch chiết thô
từ lá cây đỏ ngọn (Cratoxylum prunifolium)
Đường kính vùng ức chế xung quanh giếng thạch(mm) | ||||||
Staphylococcus auresu | Escherichia coli | Salmonella typhi | ||||
Đường kính (mm) | Hoạt tính | Đường kính (mm) | Hoạt tính | Đường kính (mm) | Hoạt tính | |
Cặn tổng (H2O) | 30 | + | 26 | + | 27 | + |
Cặn EtOAc | 29 | + | 17 | + | 18 | + |
Chú ý: Dấu (+) là phản ứng có hoạt tính.
2.4. Chiết suất, phân lập và tinh chế các chất từ cây đỏ ngọn
Từ 787,4g lá Cratoxylum prunifolium khô chiết nhiều lần bằng etanol 900 đến khi dịch chiết trong suốt không màu, loại bỏ bớt dung môi rượu bằng máy cất quay ở nhiệt độ 500C đến khi dịch chiết còn lại ở dạng xiro đặc, thêm nước, lắc cặn tổng số này với c lorofom đến khi thu được tất cả các chất có thể tan được trong CHCl3 đều được lấy ra hết, cô cạn dung dịch CHCl3 ở nhiệt độ
thấp thu đuợc 52,264g chất (kí hiệu các chất ĐC).
Phần cặn không tan trong CHCl3 được lắc nhiều lần với EtOAc cho đến khi dịch chiết EtOAc hoàn toàn không màu và trong suốt, cô cạn dịch EtOAc trong máy cất quay thu được 34,654g chất tổng số (kí hiệu là các chất ĐE).
Phần không tan được trong EtOAc, được lắc với n-butanol sau đó cũng cô cạn trong điều kiện áp suất thấp được 40,410g chất (kí hiệu là các chất ĐB).
Các chất cặn còn lại không tan trong các dung môi trên cho tan trong MeOH thu đựoc 32,346g chất (kí hiệu là các chất ĐM).
2.4.1. Dịch chiết clorofom
Từ 11g cặn từ dịch clorofom của lá đỏ ngọn kí hiệu (ĐC) được phân chia trên sắc kí cột silicagel với các hệ dung môi n-hexan - clorofom với các tỷ lệ tăng dần clorofom từ 0% đến 100% kiểm tra các phân đoạn trên sắc kí lớp mỏng, các phân đoạn giống nhau đem gộp lại và cất loại dung môi thu được ba chất ĐC-1, ĐC-2, ĐC-3.
2.4.1.1. Taraxeron (Friendoolean - 14- en-3-on) (ĐC1)
Rửa giải với các hệ dung môi n- hexan-clorofom (50:1), sau khi cất loại dung môi, cặn thu được kiểm tra trên SKLM trong hệ dung môi B và phát hiện bằng vanilin 1% trong dung dịch CH3OH- H2SO4, kết tinh lại trong dung môi trên thu được 21mg chất rắn, tinh thể hình kim, màu trắng có nhiệt độ nóng chảy 278-2800C và cho các đặc trưng của một tritecpen.
Phổ FT-IR (KBr); νmax (cm-1): 1720 (C=O); 1500 (C=C); 3050 (CH3);
2940 (CH).
Phổ LC- MS, m/z (%) 424 [M+]; 408 [M-O]+ .
PHổ 1H- NMR (500MHz, CDCl3): (ppm) 0,762ppm (3H, s, CH3); 0,84ppm (3H, s, CH3); 0,885ppm (3H, s, CH3); 0,996ppm (3H, s, CH3);
1,011ppm (3H, s, CH3); 1,02ppm (3H, s, CH3); 1,07ppm (3H, s, CH3)
5,48ppm (1H, dd, 3,21 và 8,17Hz).
Phổ 13C - NMR (500MHz, CDCl3); (ppm): 38,35 (Cl); 33,08 (C2); 217,3 (C3); 47,56 (C4); 55,77 (C5); 19,91 (C6); 33,57 (C7); 38,87 (C8); 48,80
(C9); 33,57 (C10); 17,44 (C11); 36,67 (C12); 37,74 (C13); 157,59 (C14); 117,19
(C15); 34,12 (C16); 35,57 (C17); 48,70 (C18); 40,64 (C19); 28,79 (C20); 35,11
(C21); 37,69 (C22); 29,56 (C23); 21,57 (C24); 14,79 (C25); 25,56 (C26); 29,92
(C27); 26,12 (C28); 33,39 (C29); 21,47 (C30).
2.4.1.2. Stigmast- 5,22- đien-24R-3β-ol
Rửa giải cột với hệ dung môi n-hexan- clorofom (50:5), sau khi cất loại dung môi cặn thu được kiểm tra trên SKLM trong hệ dung môi A, phát hiện bằng vanilin 1% trong dung dịch CH3OH- H2SO4, kết tinh lại trong hệ dung môi trên thu được 29mg tinh thể hình kim, không màu, không mùi, có nhiệt độ nóng chảy 152-1550C, Rf 100 =61.
Phổ FT-IR (KBr); νmax (cm-1): 3429,2 (OH); 2864,7 (C-H); 1651 (C=C).
Phổ EI- MS; m/z (%): 412 [M+] (7); 300 (7); 255 (11); 231 (4); 213
(8); 173 (7); 145 (20); 133 (20); 83 (49,3).
Phổ 1H- NMR (500MHz, CDCl3); (ppm): 5,33 (1H, dd, j = 5Hz và 2H, H6); 515 (1H, dd, j22,23 = 15, Hz, j22,20= 5Hz, H-22); 5,01 (1H, dd, j23,22 =
15Hz, j23,24 = 5Hz, H-23).
Phổ 13C- NMR (500MHz, CDCl3); (ppm): 36,4 (t, C1); 29,67 (t, C2); 71,8 (d, C3); 42,3 (t, C1); 139,2 (s, C5); 121,4 (d, C6); 37,3 (t, C7); 31,85 (d,
C8); 51,15 (d, C9); 36,12 (s, C10); 24,35 (t, C11); 42,18 (t, C12); 31,4 (s, C13);
56,83 (d, C14); 25,38 (t, C15); 31,6 (t, C16); 55,9 (d, C17); 12,01 (q, C18); 18,95
(q, C19); 40,47 (d, C20); 21,03 (q, C21); 138,4 (d, C22); 129,2 (d, C23); 50,01 (d,
C24); 33,9 (t, C25); 21,19 (q, C26); 19,79 (d, C27); 28,89 (q, C28); 12,22 (q, C29).
2.4.1.3. β- Sitosterol
Tiếp tục rửa giải trên cột với hệ dung môi n-hexan- clorofom (40:10), sau khi cất loại dung môi, cặn thu được kiểm tra trên sắc kí lớp mỏng trong hệ
dung môi B, phát hiện nó bằng vanillin 1% trong dung dịch CH3OH- H2SO4, kết tinh lại thu được 27mg chất rắn, tinh thể hình kim, nóng chảy 140- 1410C,
Rf .100 = 71.
Phổ FT-IR (KBr); νmax (cm-1): 3450 vân rộng (H32, C3); 3010- 1650
(liên kết đôi).
Phổ EI- MS; m/z (%): 414 [M+] (20); 413 [M-H]+ (41); 398 (28); 397
(100); 395 (32); 383 (11); 361 (11); 257 (3); 255 (6,3); 151 (5,6); 139 (11).
Phổ 1H-NMR (500MHz, CDCl3); (ppm): 0,68 (3H, s, CH3-18); 1,01 (3H, s, CH3-19); 0,81 (3H, d, j, 7Hz, CH3-26); 0,88 (3H, d, j, 7Hz, CH3-27);
0,83 (3H, t, 7,32Hz, CH3-29); 0,92 (3H, d, j, 10Hz, CH3-21); 3,52 (1H, m, H-
3); 5,42 (1H, d, j, 5Hz, H-6).
Phổ 13C- NMR (500MHz, CDCl3); (ppm): 141,1 (s, C5); 121,8 (d, C6); 71,8 (d, C3); 56,8 (d, C14); 56,1 (d, C17); 50,2 (d, C9); 45,7 (d, C24); 42,5
(s, C13); 42,4 (t, C4); 39,8 (t, C12); 37,3 (t, C1); 36,5 (s, C10); 36,2 (d, C20);
33,9 (d, C8); 31,9 (t, C7); 31,7 (t, C2); 29,2 (d, C25); 28,3 (t, C16); 26,2 (t, C23);
24,2 (t, C15); 21,1 (t, C11); 19,8 (q, C26); 19,4 (q, C19); 19,1 (q, C27); 18,8 (q, C21); 11,9 (q, C29); 11,9 (q, C18); 23,2 (t, C28).
2.4.2. Dịch chiết trong etylaxetat (ĐE)
Từ 15g cặn chiết etylaxetat của lá cây đỏ ngọn (ký hiệu ĐE) được tiến hành tách các chất trên sắc kí cột silicagel, rửa giải cột sắc kí bằng hệ dung môi clorofom- metanol có tỷ lệ theo độ tăng dần của dung môi phân cực, metanol 0% -100%, kiểm tra các phân đoạn trên sắc kí lớp mỏng, thuốc thử phát hiện (FeCl3 + K3[Fe(CN)6]) 1% sau đó gộp các phân đoạn giống nhau, đuổi hết dung môi và kết tinh lại thu đựơc chất (ĐE1).
* Axit gallic (ĐE1)
Rửa giải trên cột bằng hệ dung môi clorofom- metanol (90:10), sau khi kiểm tra bằng SKLM với hệ dung môi C, cất loại dung môi, thu được cặn thô, kết tinh lại trong hệ dung môi trên thu được 70mg chất rắn màu vàng, tinh thể hình kim, có tn/c khoảng 248- 2580C.
Phổ FT-IR (KBr); νmax (cm-1): 1700 (C=O); 3100 (OH) rất tù.
Phổ 1H-NMR (500MHz, MeOD); (ppm): 7,092 (2H, C2 và C6).
PHổ 13C-NMR (500MHz, MeOD); (ppm): 121,960 (C1); 139,559 (C4); 110,349 (C2, C6); 146,345 (C3, C5); 170,364 (C7).
Chương 3
THẢO LUẬN KẾT QUẢ NGHIÊN CỨU
3.1. Nguyên tắc chung
Trong quá trình nghiên cứu hóa thực vật cần phải tôn trọng nguyên tắc chung là không được làm thay đổi cấu trúc hóa học của các chất sẵn có trong thực vật và không làm ảnh hưởng đến thành phần hoá học của chúng tại thời điểm lấy mẫu. Như vậy, ngay sau khi mẫu thu hái xong phải được diệt men để tránh sự chuyển hoá do các quá trình sinh tổng hợp xảy ra ở thực vật, sấy khô ở nhiệt độ thích hợp, bảo quản mẫu trong điều kiện khô ráo.
Để tách các chất ra khỏi thực vật có thể được tiến hành bằng nhiều cách khác nhau: ép lấy dầu béo, cất lôi cuốn bằng hơi nước để tách các tinh dầu, ngâm chiết bằng dung môi hữu cơ v.v… Tuy nhiên có hai phương pháp phổ biến hơn cả để tách các chất ra khỏi thực vật:
Cách 1: Trước tiên chiết bằng dung môi rượu-nước để tách hầu hết các chất ra khỏi thực vật. Sau đó chiết sàng lọc bằng các dung môi từ không phân cực đến các dung môi có độ phân cực tăng dần. Các dịch chiết chứa các hợp chất có độ phân cực gần nhau sẽ được cất đuổi dung môi, bảo quản dùng cho các quá trình tách tiếp theo.
Cách 2: Chiết và phân lập các chất mẫu thực vật bằng các loại dung
môi từ không phân cực đến có độ phân cực tăng dần như lần lươt là: n-hexan, clorofom, etylaxetat, n-butanol, metanol(etanol), etanol-nước.
Việc chiết lấy chất từ lá thực vật (Cratoxylum prunifolium) được thực hiện theo cách 1 (sơ đồ 2.1).
Các dịch chiết tổng số và các phần chiết thô đem thử nghiệm với các tác động sinh học và độc tố tế bào nhằm giúp cho việc định hướng tìm kiếm các chất có hoạt tính sinh lý cao trong những dịch chiết.
Kết quả thử hoạt tính với vi sinh vật kiểm định nêu trong bảng (2.2)
3.2. Phân tích định tính và phát hiện các nhóm chất
Dùng các thuốc thử đặc hiệu để phát hiện các nhóm hợp chất thiên nhiên có hoạt tính sinh lý cao trong thực vật [3] cho thấy trong dịch chiết bằng clorofom của lá cây đỏ ngọn có chứa các axit hữu cơ, streroit, triterpenoit. Ở dịch chiết bằng etylaxetat của lá cây đỏ ngọn có chứa các hợp chất polyphenol, các hợp chất flavonoit, cũng ở phần dịch chiết này đã tách được axit gallic và dẫn xuất của nó. Trong dịch chiết n-butanol có chứa các tanin, các đường khử. Không phát hiện thấy có ancaloit, các xianua trong các dịch chiết của lá đỏ ngọn. Kết quả của các phản ứng định tính để xác định các nhóm hợp chất thiên nhiên có hoạt tính sinh lý cao được chỉ ra ở bảng 2.2.
3.3. Phân lập và nhận dạng các hợp chất có trong các dịch chiết khác nhau của cây đỏ ngọn
Các dịch chiết từ cây đỏ ngọn (Cratoxylum prunifolium) đều là những hỗn hợp phức tạp chứa các hợp chất khác nhau. Để phân lập từng chấ t ra khỏi hỗn hợp đã sử dụng các phương pháp sắc kí cột, chất hấp phụ dùng là silicagel, các hệ dung môi rửa giải thích hợp và thường phải lặp lại nhiều lần.
Việc tinh chế các chất thường dùng phuơng pháp kết tinh lại trong dung môi hoặc hệ dung môi thích hợp. Nhờ cách làm đó đã thu được các đơn chất có độ tinh khiết cao, đáp ứng các yêu cầu để khảo sát tính chất hoá lý và xác định quang phổ của chúng.
Khi phân lập các thành phần hoá học từ lá cây đỏ ngọn được thực hiện như trong sơ đồ 2.1. Bằng phương pháp phân lập trên, từ dịch chiết bằng clorofom của lá cây đỏ ngọn chúng tôi đã thu được 3 hợp chất sạch là: một tritecpen và hai steroit; còn dịch chiết etylaxetat phân lập được axit gallic và hỗn hợp các xanthone với flavonoit.
3.3.1. Taraxeron ( hay Frendoolean-14-en-3-on) (ĐC-1)
Chất ĐC-1 là chất rắn tinh thể hình kim, màu trắng có nhiệt độ nóng chảy ở 278-2800C nó được tách từ phần cặn chiết clorofom. Bằng sắc kí cột





![Phổ 13 C-Nmr Của Các Chất Đc-2 Và Stingmasterol [16]](https://tailieuthamkhao.com/uploads/2022/05/15/nghien-cuu-hoa-hoc-va-nhan-dang-mot-so-nhom-chat-co-trong-cay-do-ngon-6-1-120x90.jpg)
